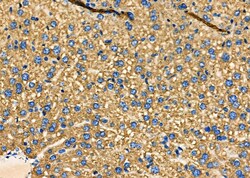
Invitrogen PUM1 Polyclonal Antibody 100 &mu;L; Unconjugated:Antibodies,
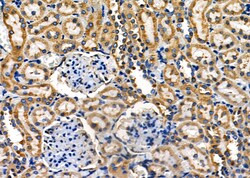
Invitrogen PUM1 Polyclonal Antibody 100 &mu;L; Unconjugated:Antibodies,

missing translation for 'onlineSavingsMsg'
Learn More
Learn More
Invitrogen™ PUM1 Polyclonal Antibody


Rabbit Polyclonal Antibody
Brand: Invitrogen™ PA5102944
This item is not returnable.
View return policy
Description
Antibody detects endogenous levels of total PUM1.
PUM1 (pumilio homolog 1) is a sequence-specific RNA-binding protein that acts as a post-transcriptional repressor by binding the 3'-UTR of mRNA targets. It is a member of the PUF family comprised of evolutionarily conserved RNA-binding proteins. PUM1 binds to an RNA consensus sequence, the Pumilio Response Element (PRE), and 5'-UGUANAUA-3' that is related to the Nanos Response Element (NRE). PUM1 mediates post-transcriptonal repression of transcripts via different mechanisms - acts via direct recruitment of the CCR4-POP2-NOT deadenylase leading to translational inhibition and mRNA degradation. Mutations to the gene can result in spinocerebellar ataxia 47.
Specifications
| PUM1 | |
| Polyclonal | |
| Unconjugated | |
| PUM1 | |
| AA517475; HsPUM; KIAA0099; mKIAA0099; PUM1; PUMH; PUMH1; pumilio 1; pumilio homolog 1; pumilio RNA binding family member 1; pumilio RNA-binding family member 1; pumilio-1; PUML1; Pumm | |
| Rabbit | |
| Affinity Chromatography | |
| RUO | |
| 80912, 9698 | |
| -20°C | |
| Liquid |
| Immunohistochemistry (Paraffin), Western Blot | |
| 1 mg/mL | |
| PBS with 50% glycerol and 0.02% sodium azide; pH 7.4 | |
| Q14671, Q80U78 | |
| PUM1 | |
| A synthesized peptide derived from human PUM1(Accession Q14671), corresponding to amino acid residues E223-G273. | |
| 100 μL | |
| Primary | |
| Human, Mouse | |
| Antibody | |
| IgG |
Product Content Correction
Your input is important to us. Please complete this form to provide feedback related to the content on this product.
Product Title
Spot an opportunity for improvement?Share a Content Correction